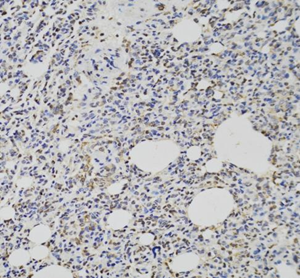
Picture 4.png

Anti-Bcl-2 Mouse mAb
- 100 μL
Product Information
Description | Bcl-2 mouse monoclonal antibody |
Protein full name | Apoptosis regulator Bcl-2 |
Synonyms | BCL2, Bcl-2, PPP1R50,B-cell CLL/lymphoma 2, apoptosis regulator |
Immunogen | KLH conjugated Synthetic peptide corresponding to Mouse Bcl-2 |
Isotype | IgG |
Purity | Affinity purification |
Subcellular location | Membrane, Mitochondrion, Mitochondrion outer membrane, Nucleus, Endoplasmic reticulum |
Uniprot ID | P10415,P49950 |
Applications
Applications | Species | Dilution | Positive Sample |
IHC/IF | Mouse, Rat | 1: 1000-1: 4000 | hepatitis, pneumonia, splenitis |
Background
Suppresses apoptosis in a variety of cell systems including factor-dependent lymphohematopoietic and neural cells. Regulates cell death by controlling the mitochondrial membrane permeability. Appears to function in a feedback loop system with caspases. Inhibits caspase activity either by preventing the release of cytochrome c from the mitochondria and/or by binding to the apoptosis-activating factor (APAF-1). May attenuate inflammation by impairing NLRP1-inflammasome activation, hence CASP1 activation and IL1B release.
Images
| Immunohistochemistry of paraffin embedded mouse hepatitis using BCL-2 (GB12318) at dilution of 1 :1000 (20x lens) |
| Immunohistochemistry of paraffin embedded mouse splenitis using BCL-2 (GB12318) at dilution of 1:1000 (20x lens) |
| Immunohistochemistry of paraffin embedded rat hepatitis using BCL-2 (GB12318) at dilution of 1:1000 (20x lens) |
| Immunohistochemistry of paraffin embedded rat pneumonia using BCL-2 (GB12318) at dilution of 1:1000 (20x lens) |
| Immunohistochemistry of paraffin embedded rat splenitis using BCL-2 (GB12318) at dilution of 1:1000 (20x lens) |
Storage
| Storage | Store at -20 ℃ for one year. Avoid repeated freeze/ thaw cycles. |
| Storage Buffer | PBS with 0.02% sodium azide, 100 μg/ml BSA and 50% glycerol. |
NOTE:
1.This product is intended for research only.
2.This product is recommended to dilute with the Primary Antibody Dilution Buffer (G2025).
| 货号 | 名称 | 规格 | 价格 | 操作 |
|---|
| 货号 | 名称 | 规格 | 价格 | 操作 |
|---|